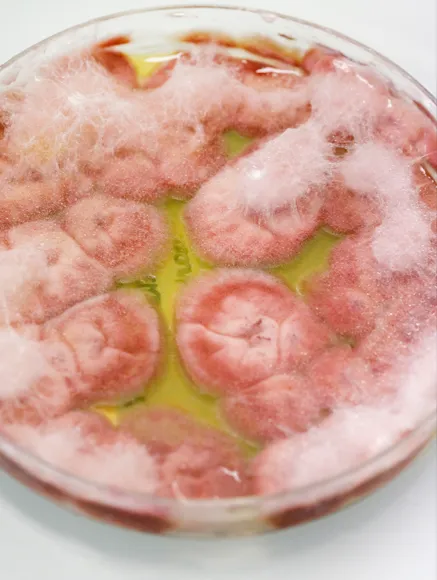

Recherche et innovation
avec un pôle dédié
Ce pôle conjugue une expertise approfondie en physiologie, biologie cellulaire et microbiologie, mettant en synergie ces connaissances avec l’intégration constante de nouvelles techniques et technologies. Le champ d’action de notre recherche ne se limite pas seulement à la biocompatibilité des dispositifs médicaux, produits chimiques, pharmaceutiques et cosmétiques, mais s’étend également à la garantie de la sécurité microbiologique.
Cette approche nous permet d’anticiper les évolutions technologiques en concevant des solutions novatrices. Nous sommes engagés dans la création et la mise en œuvre de méthodes toujours plus avancées, contribuant ainsi à l’amélioration constante de la qualité, de l’efficacité et de la sécurité des produits qui font l’objet de nos recherches.
Forts de notre engagement envers l’excellence scientifique, nous poursuivons notre quête de recherches et d’innovations. Notre ambition est de façonner l’avenir en offrant des solutions qui répondent aux besoins actuels et futurs de l’industrie médicale, chimique et cosmétique.
Le Groupe Icare s’engage en mobilisant un pôle dédié à la Recherche & Innovation.
Le Groupe Icare place l'innovation au cœur de sa mission, poursuivant deux objectifs prioritaires fondamentaux :
1. Développement de méthodes alternatives en lien avec la règle des 3R (Remplacement, Réduction, Raffinement) pour l’évaluation de la biocompatibilité des Dispositifs Médicaux
Dans notre quête constante d’amélioration, nous nous engageons à explorer et mettre en œuvre des méthodes novatrices conformes aux principes des 3R. Le remplacement, la réduction et le raffinement guident notre démarche, permettant ainsi une évaluation plus éthique, efficiente et précise de la biocompatibilité des dispositifs médicaux.
2. Optimisation de la sécurité microbiologique
La sécurité microbiologique est au cœur de nos préoccupations. Nous visons à élever les normes en développant des approches avancées et des technologies de pointe pour garantir la sécurité microbiologique dans divers domaines, allant des dispositifs médicaux aux produits chimiques, pharmaceutiques et cosmétiques.
Notre approche méthodologique en matière d'innovation s'appuie sur plusieurs piliers clés :
- Programmes internes
- Collaborations pluridisciplinaires nationales et internationales
- Développements technologiques stratégiques
En investissant dans des développements technologiques stratégiques, nous renforçons continuellement notre offre.





